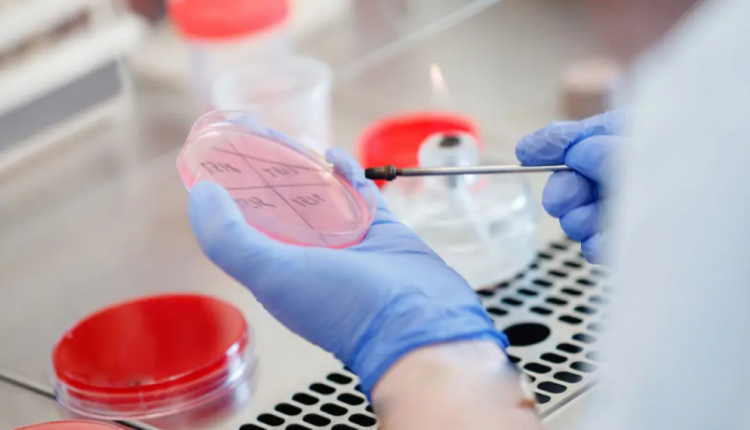

Фото:depositphotos.com
Этим летом в Акмолинской области зафиксировали 8 подтверждённых случаев заражения сибирской язвой. Как выяснилось, заболевание нашли и в других регионах, передаёт корреспондент Tengrinews.kz.
Как сообщили в Министерстве здравоохранения в ответ на официальный запрос редакции Tengrinews.kz, в июле в Казахстане зарегистрировано 7 подтверждённых случаев сибирской язвы, из них в Акмолинской области – 5 случаев (ранее сообщалось о восьми), в Карагандинской – 1 случай (пациентом оказался житель Жамбылской области), в Шымкенте – 1 случай (очаг в Туркестанской области).
«На сегодня противоэпидемические мероприятия продолжаются в одном очаге — в Туркестанской области. Все остальные очаги локализованы», — сообщили в Минздраве.
А что в Акмолинской области?
На сегодняшний день, по данным Минздрава, эпидемиологическая ситуация по сибирской язве в регионе стабильная.
«Из числа заболевших один пациент получает соответствующее лечение в инфекционном стационаре Акмолинской области, состояние здоровья удовлетворительное. Остальные выписаны из стационара в связи с выздоровлением», — сообщили в министерстве.
По состоянию на 13 августа этого года новых случаев сибирской язвы не зарегистрировано.

Комментарии закрыты.